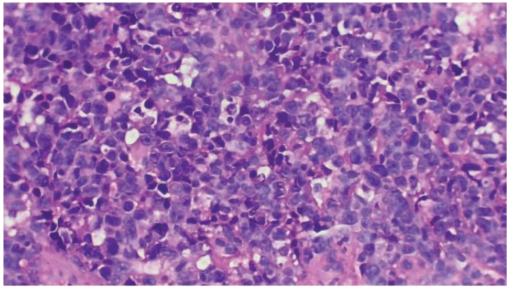
图片4.png

卡莫氟
本品主要成份为绒促性素。
苯丁酸氮芥
本品主要成份:醋酸钙
本品主要成分为醋酸兰瑞肽。
碘[I]美妥昔单抗
己烯雌酚
活性成份:可伐利单抗
可伐利单抗是一种可与补体蛋白 C5(C5)结合的重组人源化免疫球蛋白 G1(IgG1)单克隆抗体。
阿帕他胺
去铁酮。
本品主要成分为司替戊醇。
胶体磷[P]酸铬
二甲苯磺酸拉帕替尼
顺铂
本品主要成份为盐酸金刚烷胺。
本品主要成分为重组凝血因子Ⅶa。
金葡菌毒素
格拉司琼
培美曲塞二钠
本品活性成份为磷酸芦可替尼。
本品主要成分为芬戈莫德。
氯化镭[223Ra]
洛莫司汀
亮丙瑞林
本品主要成份:卡马西平
本品主要成份为曲前列尼尔。
人参多糖
马蔺子甲素
硼替佐米
丁苯那嗪
主要成份为特立氟胺。
伤寒沙门氏菌培养液纯化的Vi多糖
生物活性的多肽
左旋门冬酰胺酶
本品主要成分为丙戊酸钠。
本品主要成份为盐酸普拉克索。
复方制剂
鲨肝醇
胸腺法新
万他维主要成分为伊洛前列素。
化学名称:吡贝地尔
重组人干扰素
本品主要成份及其化学名称为:盐酸雷莫司琼
帕妥珠单抗
本品主要成份为瑞舒伐他汀钙。
本品主要成分为亚甲蓝。
本品主要成分为布洛芬。
氯膦酸二钠四水合物
活性成份为阿加糖酶β。
本品主要成分是左卡尼汀
本品主要成分为C1酯酶抑制剂。
本品主要成份为(醋酸)地塞米松。
盐酸柔红霉素
主要成分为盐酸环丙沙星。
华法林钠。
本品主要成分为氟哌啶醇。
本品主要成分为巴氯芬。
长春花碱
派安普利单抗
盐酸吡多醇。
本品主要成份为氨曲南。
恩替诺特/盐酸厄洛替尼
醋酸环丙孕酮。
本品主要成分为英夫利西单抗。
血卟啉
异环磷酰胺
本品主要成份为甲磺酸氟马替尼。
阿那曲唑
环磷酰胺
本品主要成分为妥布霉素。
薄芝糖肽
恩曲替尼
本品活性成分为硫酸氢司美替尼。
甲磺酸阿帕替尼
本品主要成分为麦格司他。
盐酸埃克替尼
本品主要成分为吡贝地尔。
盐酸阿柔比星
田参氨基酸
本片适用于特发性低促性腺激素性性腺功能减退症
亚叶酸钙
本品主要成份: 羟丁酸钠
本品的主要成分为利奥西呱。
卡莫司汀
氟他胺
本品活性成份为盐酸伊普可泮。
维奈克拉
主要成份:美沙拉秦
本品主要成分为卢非酰胺。
因卡膦酸二钠
甲苯磺酸拉帕替尼
吉西他滨
本品主要成分为盐酸金刚烷胺。
本品主要成分为林伐美卡舍明。
双环铂
雷莫司琼
盐酸米托蒽醌
本品主要成份为沙利度胺。
本品主要成分为盐酸半胱胺。
硫酸长春花碱
司莫司汀
雷替曲塞
本品的主要成份为苯妥英钠。
本品主要成分为干扰素γ-1b。
重组人粒细胞巨噬细胞集落刺激因子
大麻隆
纳武利尤单抗
阿伦单抗
本品的主要成份为西罗莫司。
从健康小牛胸腺中提取的胸腺α
盐酸小檗胺
白介素
苯巴比妥
(-)-N-(1-苯基异丙基)-N-甲基-N-丙基-氯化胺
4-羟基苯乙酸;5-羟基吲哚乙酸;苯乙酰谷氨酰胺;多肽;马尿酸
羧甲淀粉钠
重组人粒细胞-巨噬细胞集落刺激因子
瑞莫杜林主要成分曲前列尼尔。
主要成份:拉那利尤单抗
还原型谷胱甘肽
盐酸雷莫司琼
达拉非尼
主要成分为洛美他派。
活性成份为阿加糖酶β
主要成份为:吡非尼酮
江西山香药业有限公司
化学名称:奥氮平
E-氨甲环酸
本品的主要成分为艾曲泊帕乙醇胺。
本品主要成份为醋酸奥曲肽。
盐酸尼莫司汀
主要成分:依托泊苷。
本品主要成份为 2-(乙酰氧基)苯甲酸。
本品主要成分为盐酸氟奋乃静。
本品主要成分为美沙拉嗪。
醋酸奥曲肽
赛沃替尼
主要成分为富马酸喹硫平。
本品主要成分为酮康唑。
舒格利单抗
维生素B1。
西达本胺
本品主要成分为甲磺酸雷沙吉兰。
博安霉素
恩沃利单抗
本品主要成份及其化学名称为:
(Z)-N-[2-(二乙胺基)乙基-5-[(5-氟-2-氧代-1,2-二氢-3H-吲哚-3-亚基)甲基]-2,4-二甲基-3-氨
甲酰-1H-吡咯苹果酸盐
阿贝西利
甲氨蝶呤
本品主要成份为地拉罗司。
本品是由GC1菌株经液体发酵培养法制得的灵芝属薄树芝[Ganoderma capense(Lloyd )Teng]干燥菌丝体粉末中提取制得的灭菌水溶液。其组分为多糖和多肽。
紫杉醇/encequidar
本品主要成分为:艾加莫德
氟马替尼
本品主要成份为:醋酸泼尼松龙。
本品主要成分为左旋多巴。
甲磺酸多拉司琼
本品主要成分为氨己烯酸。
羟基喜树碱
硫鸟嘌呤
主要成份:重组人促卵泡激素α
阿瑞匹坦
主要成份为巴氯芬。
本品主要成分为促皮质素。
右丙亚胺
氨鲁米特
地舒单抗(RANKL 配体的免疫球蛋白 G2 全人源单克隆抗体)
西罗莫司
本品主要成分:美沙拉秦。
本品主要成分为艾替班特。
安吖啶
芦可替尼
多西他赛
本品主要成份是甲氨蝶呤
本品主要成分为安立生坦。
硫酸培洛霉素
氯膦酸二钠
盐酸多柔比星脂质体
本品主要成份为加巴喷丁
本品主要成分为盐酸硫胺素。
安西他滨
六甲蜜胺
曲普瑞林
本品主要成份为奥卡西平。
本品主要成份为托伐普坦。
重组人白细胞介素-2
斑蝥酸钠
帕博利珠单抗
西尼莫德
本品是由GC1菌株经液体发酵培养法制得的灵芝属薄树芝[Ganoderma capense
(Lloyd )Teng]干燥菌丝体粉末中提取制得的灭菌水溶液。其组分为多糖和多肽。
重组人粒细胞巨噬细胞刺激因子
含胸腺素α
右雷佐生
定位
本品的主要成份为盐酸司来吉兰
抗Tac单抗
a-甘露聚糖肽
人血白蛋白
艾思瑞主要成份为:吡非尼酮。
本品主要成份为:氯苯唑酸
薏苡仁油甘油三酯
硫酸羟氯喹
培唑帕尼
米泊美生
本品主要成分为地夫可特。
本品主要成份为波生坦。
替尼泊苷
测试
色甘酸钠
本品主要成分为依泊汀-θ。
本品主要成分为瑞舒伐他汀钙。
羟喜树碱
本品主要成份地西泮。
本品含氯化钾(KCl) 应为标示量的95.0%~105.0%。
本品主要成分为西妥昔单抗。
本品主要成份为西罗莫司。
本品主要成份为醋酸亮丙瑞林。
泊马度胺
盐酸精氨酸。
本品主要成分为D-3-巯基-缬氨酸。
重组人CD22单克隆抗体
醋酸甲羟孕酮。
他莫昔芬
本品主要成分为托吡酯。
三尖杉酯碱
阿基仑赛
本最主要成份为瑞派替尼。
来那度胺
依托泊苷
本品主要成分为甲状旁腺激素。
本品每20 ml溶液含:活性成分:西妥昔单抗 100 mg其它成分:氯化钠 116.88 mg;甘氨酸 150.14 mg;聚山梨酯80 2 mg;一水合柠楼酸 42.02 mg;氢氧化钠(1M) 调节PH直至55;注射用水 加至20 ml。
纳武利尤单抗/瑞拉利单抗
本品主要活性成份为阿伐替尼
哌柏西利
本品主要成份为:甲泼尼龙琥珀酸钠。
本品主要成分为醋酸锌。
重组人粒细胞集落刺激因子
盐酸伊达比星
本片适用于治疗多发性硬化
克唑替尼
活性成份:巴氯芬。
本品主要成分为恩他卡朋。
尿多酸肽
醋酸甲地孕酮
活性成分:伊匹木单抗
醋酸戈舍瑞林
化学名称:5-氨基水杨酸
本品主要成分为去铁酮。
福莫司汀
甲磺酸阿美替尼
卡铂
本品主要成份为甲氨蝶呤。
本品是由GC1菌株经液体发酵培养法制得的灵芝属薄树芝干燥菌丝体粉末中提取制得的灭菌水溶液。其组分为多糖和多肽。
去甲斑蟊酸钠
乌苯美司
达卡巴嗪
本品主要成份为硫唑嘌呤。
本品主要成分为抗坏血酸钠。
醋酸亮丙瑞林
甲基斑蝥胺
重组人血管内皮抑制素
本品主要成份为青霉胺。
地塞米松棕榈酸酯
胸腺a
乙双吗啉
达雷妥尤单抗
芬戈莫德
活性成份:恩他卡朋
胸腺肽α1
甘露聚糖肽
伊尼妥单抗
本品主要成份为安立生坦
主要活性成分:托珠单抗
巴利昔单抗
自新鲜猪脾脏中提取的多肽及核苷酸类物质
磷
本品主要成份为:乙磺酸尼达尼布
本品主要成分为:氯苯唑酸葡胺
碘[I]
乌骨藤
塞瑞替尼
本品活性成份为氨吡啶
本品为主要成分为免疫球蛋白。
本品的主要成分为叶酸。
盐酸伊立替康
本品主要成分为醋酸钙。
本品主要成分为妥布霉素
本品主要成分为硫唑嘌呤。
本品主要成份为环孢素。
克拉屈滨
主要成分为考来烯胺。
螺内酯
本品主要成份为来那度胺。
本品主要成分为氨甲环酸。
布格替尼
骨化三醇
本品主要成分为依达拉奉。
长春瑞滨双酒石酸盐
本品主要成分为来曲唑。
依西美坦
本品主要成份为人单克隆免疫球蛋白G2(IgG2)。
亚胺醌
瑞维鲁胺
本品主要成分为替莫唑胺。
吉非替尼
酒石酸长春瑞滨
本品主要成份为盐酸罗匹尼罗。
氨磷汀
磷酸氟达拉滨
本品适用于治疗纯合子家族性高胆固醇血症
奥布替尼
本品主要成份为:甲泼尼龙
本品主要成分为溴吡斯的明。
榄香烯
美法仑
活性成份:盐酸奥扎莫德
阿法替尼
本品化学名称为:羟基脲
羟丁酸钠注射液:本品的主要成分为羟丁酸钠。
去甲斑蝥酸钠
氮甲
维生素B
本品活性成份:马昔腾坦
本品主要成分为氘代丁苯那嗪。
碘[131I]肿瘤细胞核人鼠嵌合单克隆抗体
盐酸恩沙替尼
奥沙利铂
本品主要成份为利培酮。
本品主要成份重组人干扰素β-1b。
亚叶酸钠
云芝胞内糖肽
地西他滨
本品主要成份为他克莫司。
本品主要成分为左卡尼汀。
A群链球菌
氯氧喹
尼妥珠单抗
本品主要成份:硫酸锌
本品主要成份是托伐普坦。
蛋白质中95%以上为免疫球蛋白
伊沙佐米
度伐利尤单抗
本品主要成分为癸氟奋乃静。
化学名称:N-2-炔丙基-1(R)--氨基茚甲磺酸盐
重组人粒细胞刺激因子其来源
健康牛胸腺提取含生物活性的多肽类物质
普拉曲沙
本品活性成份:马昔腾坦
活性成分:Elosulfase alfa是利用重组DNA技术由中国仓鼠卵巢(CHO)细胞表达制备的重组人N-乙酰半乳糖胺-6-硫酸酯酶(rhGALNS)。
阿达木单抗
阿魏酸钠
苦参碱
重组人干扰素。
本品活性成份:司来帕格
硼替佐米
硫唑嘌呤
尼拉帕利
本品主要成分为甲泼尼龙琥珀酸钠
本品主要活性成分为重组利妥昔单抗。
本品主要成分为布洛芬。
肠毒素C
本品主要成分为培维索孟。
本品主要成份为地拉罗司。
本品主要成份为甲氨蝶呤。
本品主要成分为盐酸胺碘酮。
盐酸博莱霉素
本品主要成分为盐酸金刚烷胺。
本品主要成分为碳酸氢钠
活性成份:艾曲泊帕乙醇胺。
本品各类制剂的主要成份为他克莫司。
维迪西妥单抗
十一酸睾酮。
本品主要成分为吡非尼酮。
多柔比星
本品主要成分为格列本脲。
枸橼酸托瑞米芬
本品主要成分为阿巴西普。
盐酸槐定碱
斯鲁利单抗
本品活性成份为氯巴占
盐酸厄洛替尼
卡培他滨
本品主要成分为亚甲蓝。
甘氨双唑钠
羟基脲
辛伐他汀片
甲磺酸伏美替尼
活性成分:奥氮平
本品主要成分为戈利木单抗。
纳米炭
白消安
本片适用于治疗视网膜母细胞瘤
凡德他尼
本品主要成份为安立生坦。
本品主要成份伊洛前列素。
氯化锶[Sr]
甲磺酸奥希替尼
环孢素
艾度硫酸酯酶β
本品主要成分为丁苯那嗪。
磺巯嘌呤
托烷司琼
奈达铂
本品主要成分为拉莫三嗪
本品主要成分为二盐酸沙丙蝶呤。
油酸多相脂质体
苦参素
洛铂
本品主要成份为癸氟奋乃静。
本品主要成分为乙氨醇艾曲波帕。
人免疫球蛋白
甲异靛
曲妥珠单抗
本品主要成份为阿立哌唑。
主要成分为亚甲蓝
胸腺α
炔雌醇
替雷利珠单抗
本品主要成分为卡马西平。
本品主要成份为利鲁唑。
本品蛋白质中95%以上为免疫球蛋白
健康牛脾脏为原料
贝林妥欧单抗
司妥昔单抗。
活性成份:巴氯芬
甘露醇和氯化钠
茜草双酯
喜树碱
本品活性成份为帕米膦酸二钠。
本品主要成份为:利奥西呱
乙磺酸尼达尼布
麦考酚酸
地舒单抗
主要成分为他达拉非。
本品主要成分为环磷酰胺。
本品主要成份为枸橼酸西地那非。
硫酸长春地辛
本品主要成分为美曲普汀。
本品主要成分为美曲普汀。
本品主要成分为奥氮平。
本品主要成分为艾地苯醌。
高三尖杉酯碱
泽贝妥单抗
本品主要成分及其化学名:本品主要成分为达那唑。
活性成份:利司扑兰(risdiplam)
本品主要成分为拉莫三嗪。
亚叶酸钙/盐酸伊立替康/氟尿嘧啶
戊酸雌二醇。
本品主要成分为左乙拉西坦。
硫酸长春新碱
伊匹木单抗
硫酸新霉素。
比卡鲁胺
本品主要成分为达那唑。
抗肿瘤免疫核糖核酸
甲磺酸贝福替尼
本品主要成分为培美曲塞二钠。
甲磺酸伊马替尼
活性成份:艾美赛珠单抗
替吉奥
本品主要成分为依那西普。
硝卡芥
替加氟
本品适用于纯合子家族性高胆固醇血症
卡博替尼
活性成份:利培酮
本品主要成分为吗替麦考酚酯。
盐酸平阳霉素
转移因子
本片适用于重症先天性粒细胞缺乏症
瑞戈非尼
化学名称:(+)-(2S)-2-[(4,6-二甲基嘧啶-2-基)氧基]-3-甲氧基-3,3-二苯基丙酸
本品主要成分为司妥昔单抗。
亚砷酸
甲苯磺酸索拉非尼
吗替麦考酚酯
本品主要成分为卡比多巴和左旋多巴。
本品主要成分为甲磺酸洛美他派。
卫矛醇
阿扎司琼
盐酸表柔比星
本品主要成份为环孢素。
本品主要成分为他达拉非。
枸橼酸托烷司琼
去甲斑蝥素
盐酸多柔比星
本品主要成份为氟哌啶醇。
本品主要成分为阿达木单抗。
α-甘露聚糖肽
维莫德吉
贝伐珠单抗
本品主要成份为丙戊酸钠。
醋酸去氨加压素。
辅酶A
格列本脲
卡瑞利珠单抗
本品主要成份为苯妥英钠。
本品活性成份为诺西那生钠。
本品蛋白质中95%以上为人免疫球蛋白
银耳多糖
氟维司群
重组人凝血因子Ⅷ。
本品主要成份为∶溴吡斯的明
左亚叶酸钙
来氟米特
恩美曲妥珠单抗
主要成分托吡酯。
活性成分:阿达木单抗40mg。辅 料:枸橼酸钠;枸橼酸;磷酸二氢钠;磷酸氢二钠;蔗糖;聚山梨酯80;氢氧化钠
本品主要成份为左氧氟沙星。
咪唑立宾
维布妥昔单抗
枸橼酸西地那非。
本品主要成分为米托蒽醌。
本品主要成分为甘露醇。
氟脲苷
本品主要成分为盐酸阿那格雷。
艾曲泊帕乙醇胺
本品主要成分为利培酮。
本品主要成分为盐酸普拉克索。
依那西普
食道平散
本品每片含门冬氨酸钾(C4H6NO4K)158mg和门冬氨酸镁[(C4H6NO4)2Mg]140mg。
活性成分:重组人类酸性 α-葡萄糖苷酶
本品主要成份为加巴喷丁。
瑞派替尼
本品是前列环素(PGI2)的衍生物。
本品主要成分为色甘酸钠。
醋酸曲普瑞林
地舒单抗
本品化学名称为:硫酸长春新碱。
来曲唑
本品主要成份为诺西那生钠。
黄芪多糖
达尔西利
本品活性成份为泽布替尼
尼洛替尼
活性成分:拉罗尼酶
氟尿嘧啶
本品主要成分为醋酸亮丙瑞林。
盐酸博来霉素
盐酸拓扑替康
阿托伐他汀钙
依维莫司
盐酸普拉克索
本品主要成分为依库珠单抗。
重组人p53腺病毒
磷酸雌莫司汀
本品的活性成份为醋酸锌。
维莫非尼
本品是由GC1菌株经液体发酵培养法制得的灵芝属薄树芝[Ganoderma capense(Lloyd )Teng]干燥菌丝体粉末中提取制得的灭菌水溶液。其组分为多糖和多肽。
本品主要成分为盐酸美西律。
重组人5型腺病毒
苹果酸舒尼替尼
沙利度胺
主要成分:达依泊汀 α
本品主要成份为重组凝血因子Ⅸ。
阿立必利
昂丹司琼
盐酸托泊替康
活性成分:依库珠单抗是采用重组 DNA 技术由鼠源骨髓瘤细胞系 NS0 细胞表达制备的抗人补体蛋白 C5 人源化单克隆抗体(IgG2/4κ)。
辅料: 磷酸二氢钠
磷酸氢二钠
氯化钠
聚山梨酯 80
注射用水
本品主要成分为托珠单抗。
槲寄生
利可君
盐酸吡柔比星
本品主要成份为左旋多巴。
本品的主要成分为马昔腾坦。
破伤风人免疫球蛋白
甘磷酰芥
西妥昔单抗
本品主要为替硝苯那嗪
主要成份为∶吡非尼酮
健康乳牛(出生24小时内)脾脏为原料提取而成
匹多莫德
唑来膦酸
本品主要成分为奥卡西平。
本品主要成份:盐酸普拉克索。
抗人T细胞猪免疫球蛋白
胸腺肽
重组人粒细胞刺激因子
盐酸沙丙蝶呤。
本品主要成份为艾地苯醌。
多磺酸粘多糖
氧化苦参碱
曲美替尼
主要成分依维莫司。
本品主要成份及化学名称为:醋酸兰瑞肽。
本品的主要成分为叶酸。
紫芝多糖粉
本品主要成分为利鲁唑。
本品主要成份为海曲泊帕乙醇胺
本品主要成分为那他珠单抗。
本品主要成分为秋水仙碱。
放线菌素D
本品主要成份为:阿奇霉素。
本品主要成份为更昔洛韦。
本品主要成份为阿立哌唑
本品主要成分为甲泼尼龙。
盐酸氮芥
碳酸钙
本品主要成份对乙酰氨基酚。
本品主要成分为盐酸司来吉兰。
盐酸胍
化学名称为:3α,7β-二羟基-5β-胆甾烷-24-酸。
本品的主要成分为乙磺酸尼达尼布。
福美坦
司妥昔单抗
本品主要成份为:甲硫酸新斯的明。其化学名称为:N,N,N-三甲基-3-[(二甲氨基)甲酰氧基]苯铵甲基硫酸盐。分子式:C13H22N2O6S分子量:334.39
醋酸甲羟孕酮
本品主要成分为去醋酸氨加压素。
重组改构人肿瘤坏死因子
本品活性成份为盐酸替洛利生。
达沙替尼
本品主要成份为伊米苷酶。
门冬酰胺
本品主要成份为特立氟胺。
新福菌素
去氧氟尿苷
本品适用于特发性低促性腺激素性性腺功能减退症
帕洛诺司琼
主要成分:酸去氨加压素
奥拉帕利(olaparib)
奥希替尼(osimertinib)
泊马度胺(pomalidomide)
尼拉帕利(niraparib)
LOXO-101
替西罗莫司(temsirolimus)
T-DM1
Rituximab
idelalisib
伊马替尼(imatinib)
darolutamide
阿柏西普(aflibercept)
SHR-1210
帕妥珠单抗(pertuzumab)
奥妥珠单抗
维莫非尼( vemurafenib)
PD-1
培美曲赛(pemetrexed)
Brigatinib
拓扑替康(topotecancas)
mirvetuximab soravtansine
信迪利单抗
赛沃替尼(Savolitinib)
本妥昔单抗(Brentuximab)
Zanidatamab
劳拉替尼
Lutathera
曲贝替定(trabectedin)
abemaciclib
鲁卡帕尼(rucaparib)
prexasertib
5-FU
卡培他滨(capecitabine)
达拉非尼(dabrafenib)
阿比特龙
吉非替尼( gefitinib)
存达®
贝伐珠单抗(bevacizumab)
苯达莫司汀
奥沙利铂(oxaliplatin)
色瑞替尼
纳武利尤单抗(nivolumab)
帕尼单抗(panitumumab)
哌柏西利(palbociclib)
PD-L1
阿柔比星(aclarubicin)
阿美替尼
依托泊苷(etoposide)
多纳非尼
王宝成
氟唑帕利
Zanubrutinib
WCLC
伊匹木单抗(ipilimumab)
阿扎胞苷
alisertib
达卡巴嗪(dacarbazine)
伊马替尼
apalutamide
三氧化二砷
培美曲塞(pemetrexed)
曲美替尼(trametinib)
沃利替尼
厄洛替尼(erlotinib)
neratinib
曲妥珠单抗(trastuzumab)
dinutuximab beta
卡铂(carboplatin)
Savolitinib
瑞戈非尼(ruigefeinipian)
阿糖胞苷
多西他赛(docetaxe)
Imfinzi
博来霉素(bleomycin)
阿替利珠单抗
多柔比星( doxorubicin)
tiragolumab
伊布替尼
Bemarituzumab
仑伐替尼
IASLC
恩杂鲁胺(enzalutamide)
卡非佐米(Carfilzomib)
乐伐替尼(lenvatinib)
帕唑帕尼(pazopanib)
二甲双胍(metformin)
埃克替尼(icotinib)
他莫昔芬(tamoxifen)
聚乙二醇脂质体多柔比星
duvelisib
安罗替尼
Durvalumab
拉帕替尼(lapatinib)
avelumab
西妥昔单抗(cetuximab)
CPX-351
顺铂(cisplatin)
巯嘌呤
尼达尼布(nintedanib)
ribociclib
奥西布宁(oxybutynin)
avapritinib
表柔比星(epirubicin)
恩扎卢胺
帕博利珠单抗(pembrolizumab)
氢吗啡酮
西奥罗尼
Dostarlimab
紫杉醇
新辅助
encorafenib
奥拉单抗(Olaratumab)
呋喹替尼(fruquintinib)
尼洛替尼(nilotinib)
雷莫芦单抗(ramucirumab)
卢卡帕利(rucaparib)
平阳霉素
Lurbinectedin
度伐鲁单抗(durvalumab)
trebananib
戈舍瑞林
舒尼替尼(sunitinib)
entrectinib
卡铂他滨(capecitabine)
伊匹单抗
阿帕替尼(apatinib )
阿那曲唑(anastrozole)
曲氟尿苷替匹嘧啶
来曲唑(letrozole)
奈拉替尼(neratinib)
伊立替康(irinotecan)
Tepotinib
卡瑞利珠单抗(camrelizumab)
Ivosidenib
吡咯替尼
LCMC3
贝美替尼(binimetinib)
ibalizumab-uiyk
仑伐替尼(lenvatinib)
依度沙班(edoxaban)
奥法木单抗(ofatumumab)
氟维司群(fulvestrant)
丝裂霉素
Gardasil 9
布加替尼( brigatinib )
阿法替尼(afatinib)
CAN04(nidanilimab)
阿昔替尼(axitinib)
abivertinib
依维莫司(everolimus )
lorlatinib
硼替佐米(bortezomib)
tremelimumab
依西美旦( exemestane)
pemigatinib
托瑞米芬(toremifene)
SAR408701
吉西他滨(gemcitabine)
spartalizumab
替雷利珠单抗(tislelizumab)
Infigratinib
阿来替尼
Enfortumab Vedotin
Erdafitinib
艾日布林(eribulin)
吡咯替尼(pyrotinib)
YS-ON-001
凡德他尼(vandetanib)
替莫唑胺
alpelisib
恩美曲妥珠单抗(Kadcyla)
S-1
利妥昔单抗
克唑替尼(crizotinib)
Namdenoson
培唑帕尼(pazopanib)
美法仑(melphalan)
泽布替尼
来那度胺(lenalidomide)
聚乙二醇化IL-10
福美坦(formestane)
拉罗替尼(larotrectinib)
他莫西芬(tamoxifen)
Trastuzumab deruxtecan
特瑞普利单抗
塞瑞替尼(ceritinib)
奥曲肽
呋喹替尼
Selpercatinib(LOXO-292)
伊布替尼(Ibrutinib)
aldoxorubicin
奈达铂(nedaplatin)
奥拉帕利
larotrectinib
卡博替尼(cabozantinib)
Talazoparib
白蛋白结合型紫杉醇
venetoclax
阿特珠单抗(atezolizumab)
达可替尼
达沙替尼(dasatinib)
Birinapant
索拉非尼(sorafenib )
IBI305
甲氨蝶呤(methotrexate)
奈拉滨(nelarabine)
达卡巴嗪(dacarbazine)
氨鲁米特(aminoglutethimide)
法米替尼(famitinib)
环磷酰胺(cyclophosphamide)
DS-8201
赞鲁替尼(zanubrutinib)
本妥昔单抗
索凡替尼
紫杉醇脂质体
Mobocertinib (TAK-788)
brentuximab vedotin
测试使用药物标签
曲贝替定(trabectedin)

苏公网安备32059002004080号
苏公网安备32059002004080号


